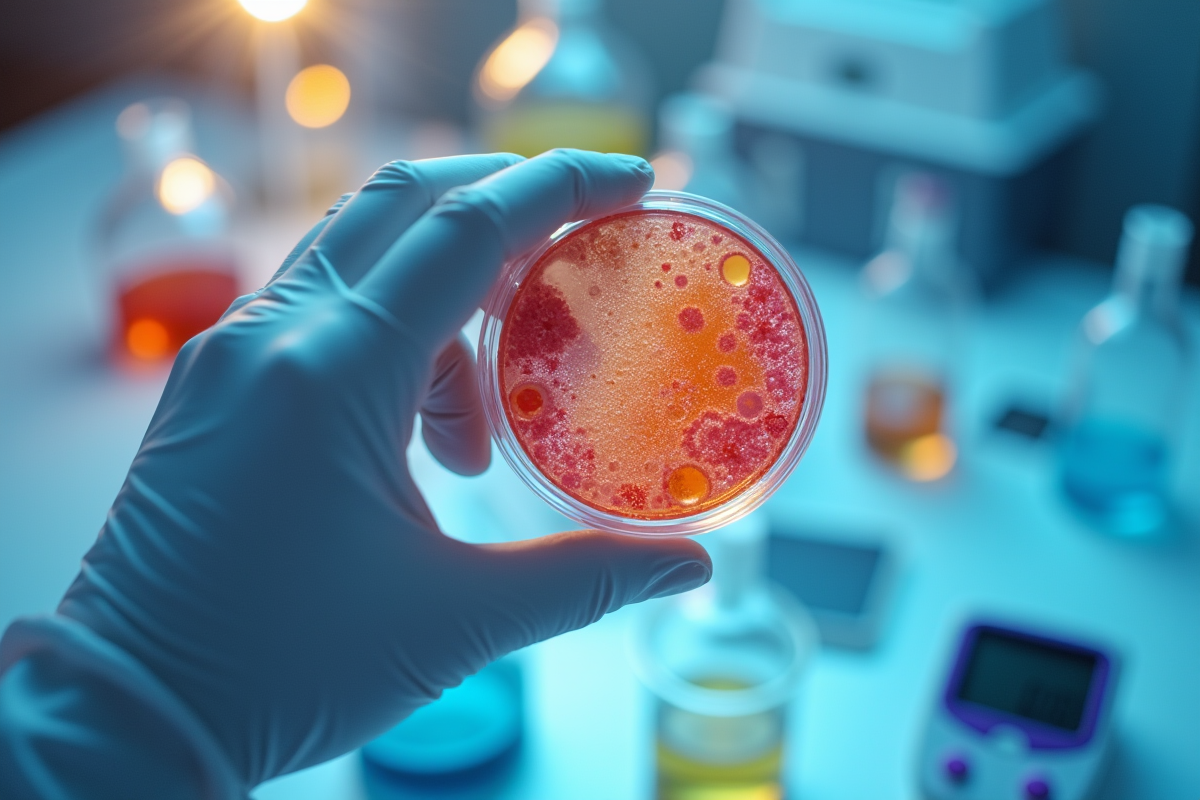

Un pot de chou fermenté n’a jamais attendu d’être parfait pour se transformer : la fermentation rapide, c’est l’art de bousculer l’ordre établi, de gagner sur le temps sans rien sacrifier à la magie du vivant. En modifiant le ratio sel-eau ou la température ambiante, il devient possible de réduire considérablement le temps nécessaire à la transformation des aliments par les micro-organismes. Certains ferments commerciaux, ensemencés avec des souches sélectionnées, court-circuitent d’ailleurs les étapes classiques et bousculent les protocoles traditionnels.
Des pratiques ancestrales connaissent aujourd’hui des variantes express, portées par la recherche de résultats rapides sans équipements complexes. La maîtrise de quelques paramètres clés suffit à ouvrir la voie à une fermentation maison plus accessible et immédiate.
A lire en complément : Légumes lacto-fermentés : découvrez les meilleurs choix pour votre santé !
La fermentation rapide, une solution naturelle pour gagner du temps en cuisine
La fermentation rapide s’impose désormais comme une méthode de conservation à la fois efficace et respectueuse de la nature des produits. Ce procédé écourte le temps de transformation des aliments sans rien ôter à la richesse des saveurs ni aux bienfaits pour la santé. Les bactéries lactiques prennent la main : ces micro-organismes transforment les sucres en acide lactique, ce qui assure à la fois goût, texture et sécurité alimentaire.
Pour accélérer ce processus de fermentation, il faut jouer sur plusieurs leviers. Température, humidité, dosage du sel, tout compte. Une chaleur modérée (autour de 22 à 25°C) favorise l’activité microbienne, tandis que des légumes découpés finement offrent plus de surface, ce qui rend la fermentation plus active.
A voir aussi : Yaourts bien fermes : astuces pour réussir à coup sûr !
Les adeptes de rapidité en cuisine trouvent dans la lacto-fermentation un allié précieux : un chou ou quelques carottes se métamorphosent en aliments fermentés prêts à l’emploi en seulement quelques jours. Simplicité, rapidité et authenticité séduisent ceux qui veulent conjuguer tradition et modernité, tout en profitant des vertus de la cuisine vivante.
Voici les leviers qui font la différence dans la réussite d’une fermentation accélérée :
- Maîtrisez la coupe : plus le légume est fin, plus la fermentation s’accélère.
- Adaptez la saumure : un dosage précis stimule le travail des micro-organismes.
- Surveillez la température : ni trop froide, ni trop chaude pour une fermentation optimale.
La fermentation rapide ne se contente pas de raccourcir les délais : elle insuffle une nouvelle énergie à nos habitudes culinaires, tout en restant fidèle à des gestes simples et naturels.
Quels sont les principes qui accélèrent le processus de fermentation ?
La fermentation rapide tient son efficacité d’un réglage précis des facteurs biologiques et physiques qui orchestrent l’action des bactéries lactiques et des levures sauvages. Dans ce ballet invisible, chaque détail compte.
Le rôle de la température
Contrôler la température, c’est donner le tempo aux micro-organismes responsables de la transformation. Entre 22 et 28°C, la production d’acide lactique s’accélère et la fermentation bat son plein. Si la température chute, le rythme ralentit. Au-delà, certains ferments fatiguent, et des indésirables peuvent s’installer.
Pour optimiser ce processus, plusieurs gestes sont à privilégier :
- Finement découpés, les légumes offrent une surface idéale à la colonisation microbienne. Plus la découpe est fine, plus la fermentation démarre vite.
- Le sel, bien dosé, favorise la sélection des agents bénéfiques et freine les pathogènes.
- Un taux d’humidité maîtrisé garantit la mobilité des micro-organismes et la diffusion des nutriments.
La méthode gagne encore en efficacité grâce à l’aération contrôlée : un bocal hermétique équipé d’un joint laisse échapper le gaz carbonique, tout en préservant le contenu de l’oxygène. Ce détail protège le goût et la qualité du résultat.
Ajouter un peu de jus de fermentation d’un précédent bocal, riche en levures sauvages et bactéries actives, permet de donner un coup d’accélérateur naturel. La fermentation démarre plus vite, les arômes se révèlent mieux et la conservation s’allonge, tout en restant sûre.
Petites astuces et gestes malins pour réussir sa lacto-fermentation à la maison
Maîtriser les fondamentaux
Pour mettre toutes les chances de votre côté, misez sur la simplicité : des légumes frais, un sel de qualité (non iodé, non fluoré), une eau pure (filtrée ou de source) et des bocaux impeccables, de préférence en verre épais. La propreté du matériel et la précision dans les gestes font toute la différence.
Voici les étapes à respecter pour garantir une fermentation efficace :
- Pesez vos légumes : le ratio classique reste 2 % de sel par rapport au poids total. Ce dosage favorise le développement des bactéries lactiques et assure une saumure protectrice.
- Préparez une saumure à froid pour les légumes entiers, ou lancez une fermentation au sel direct pour les légumes râpés. Pressez-les légèrement pour accélérer l’extraction naturelle de leur eau.
Optimiser le milieu de fermentation
Il est conseillé de bien tasser les légumes dans le bocal afin d’exclure l’air et d’empêcher le développement des levures indésirables. Si besoin, utilisez un poids adapté ou un petit galet stérilisé pour les maintenir sous la saumure. Le liquide doit toujours recouvrir l’ensemble, la méthode restant strictement anaérobie.
Placez le bocal à température ambiante, à l’abri de la lumière. L’apparition de petites bulles indique que la fermentation est en marche. Un couvercle à joint ou une valve d’évacuation permet de libérer la pression tout en réduisant les risques de moisissures.
Les deux premiers jours sont décisifs. Si la température se situe entre 20 et 24°C, la lacto-fermentation démarre rapidement. Ensuite, rangez le bocal dans un lieu plus frais pour affiner les arômes et prolonger la conservation.
Des idées d’aliments à fermenter facilement pour se lancer sans stress
Légumes, fruits et boissons pétillantes : la simplicité à portée de bocal
Il suffit d’un bocal impeccable, de quelques légumes de saison et de laisser faire la nature. Le chou, les carottes ou le radis noir sont des références en fermentation rapide. Leur texture ferme, leur richesse en fibres et leur apport en sucres naturels stimulent les bactéries lactiques. Après avoir tranché, salé et tassé les légumes, les premiers pickles maison apparaîtront en quelques jours.
Voici quelques pistes inspirantes pour varier vos préparations :
- Le chou chinois et les carottes forment la base du kimchi coréen. En y ajoutant ail, gingembre et piment, on stimule la lacto fermentation et on élargit la palette aromatique.
- Les fruits aussi se prêtent au jeu. Pommes, poires, prunes : quelques quartiers, un soupçon de sel, et la fermentation met en valeur des saveurs inattendues, parfaites en accompagnement ou pour un dessert original.
- Pour ceux qui aiment les boissons originales, essayez une boisson pétillante fermentée à base d’épluchures de pommes ou de gingembre. La fermentation naturelle crée une effervescence délicate, sans ajout de levures.
Adaptez la découpe selon vos envies : bâtonnets croquants, fines lamelles ou légumes entiers. Cette méthode de conservation s’adapte à toutes les préférences. Quelques jours de patience, une température stable, et la transformation s’opère. Les aliments fermentés apportent du caractère à vos plats, multiplient les saveurs et invitent la diversité microbienne dans votre assiette, pour un coup de pouce à la santé.
Un bocal, quelques gestes précis, la chaleur de la maison : la fermentation rapide s’invite dans le quotidien et, en quelques jours, réinvente la notion de patience. Le temps n’attend pas, la fermentation non plus.

